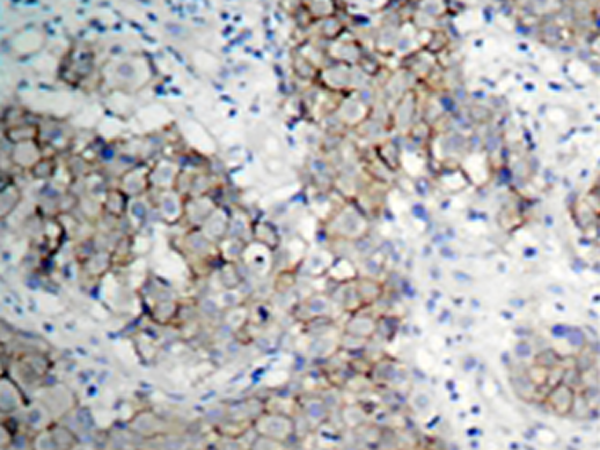

Background:
This receptor binds insulin-like growth factor with a high affinity. It has tyrosine kinase activity. The insulin-like growth factor I receptor plays a critical role in transformation events. Cleavage of the precursor generates alpha and beta subunits. It is highly overexpressed in most malignant tissues where it functions as an anti-apoptotic agent by enhancing cell survival. Alternatively spliced transcript variants encoding distinct isoforms have been found for this gene.
Applications:
WB, IHC, IF
Name of antibody:
IGF1R(Phospho-Tyr1161)
Immunogen:
Peptide sequence around phosphorylation site of tyrosine 1161(D-I-Y(p)-E-T)derived from Human IGF-1R.
Full name:
insulin-like growth factor 1 receptor
Synonyms:
IGFR; CD221; IGFIR; JTK13
SwissProt:
P08069
IHC positive control:
Human breast carcinoma tissue
IHC Recommend dilution:
50-100
WB Predicted band size:
155 kDa
WB Positive control:
293 cells lysates untreated or treated with insulin
WB Recommended dilution:
500-1000
IF positive control:
MCF7 cells
IF Recommend dilution:
100-200
技術規(guī)格

購物車
幫助
021-54845833/15800441009
